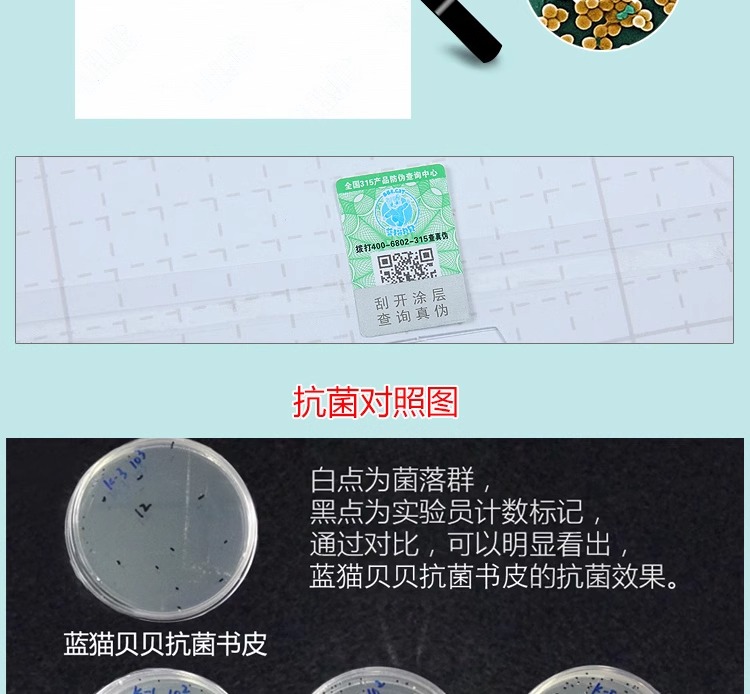
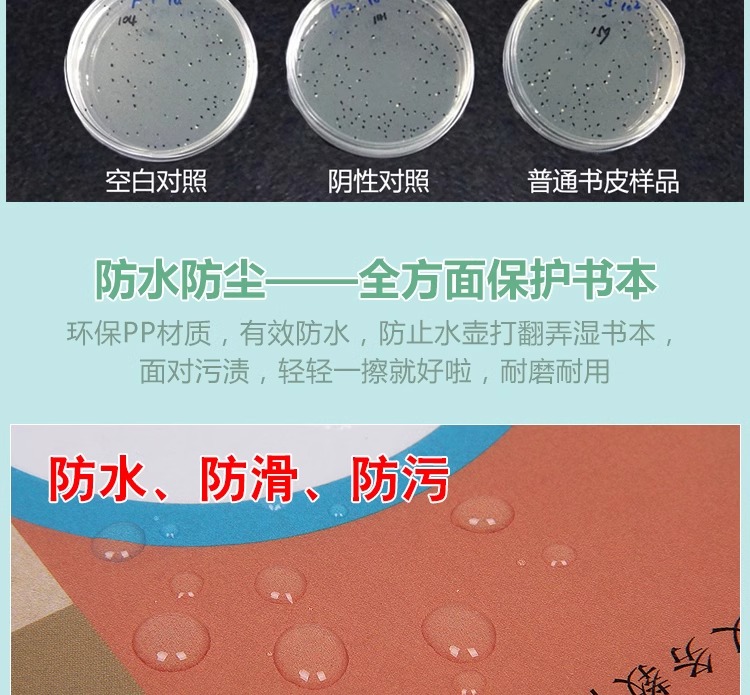

蓝猫贝贝抗菌自粘书皮书套书皮纸磨砂透明包书皮包书膜16K全套小学生a4一二年级上册书壳塑料加厚防水保护套
¥15.00 - 32.00
| 运费: | ¥ 6.00-18.00 |
商品详情

- 余姚智慧书屋 (微信公众号认证)
- 本店铺主营小学初中各类教辅资料,名著阅读等 欢迎进店咨询!
- 扫描二维码,访问我们的微信店铺
- 随时随地的购物、客服咨询、查询订单和物流...